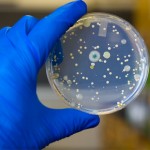
Superbugs are Killing Us

by Dr. Clark Hansen, NMD | Jun 18, 2011 | Health Condition, Health Research
June 9, 2011 – The US Food and Drug Administration has just alerted healthcare professionals about changes in the labeling of 5-alpha reductase inhibiting drugs (5-ARI). These drugs for Benign Prostate Hypertrophy (BPH), include finasteride (Proscar) and...

by Dr. Clark Hansen, NMD | Jun 16, 2011 | Fitness and Health, Food and Nutrition, Health Condition
A handful of Pistachio nuts eaten every day has been shown to significantly improve chronic erectile dysfunction in as little as three weeks. Erectile Dysfunction (ED) is thought to be a sign of cardiovascular disease risk because the same processes needed to maintain...

by Dr. Clark Hansen, NMD | Jun 11, 2011 | Food and Nutrition, Health Research
May 24, 2011. Drug-resistant bacteria—“superbugsâ€â€”are becoming a global crisis. But the government not only thwarts the development of new antibiotic drugs. It also willfully ignores...

by Dr. Clark Hansen, NMD | Jun 11, 2011 | Fitness and Health, Health Research, Medical Tests, Men's Health, Women's Health
May 24, 2011.  Call it the sledgehammer approach to medicine. Rather than catching or curing disease, aggressive cancer screenings and unnecessary biopsies are actually causing cancer, spreading deadly “superbugs†and...
by Dr. Clark Hansen, NMD | Mar 15, 2011 | Health Condition, Health Research
When it comes to the nuclear-power disaster unfolding in Japan, there clearly is far more to fear than fear itself. But fear is clearly one of the biggest – and could turn out to be the most potent – dangers. Although radiation escaping from a nuclear...